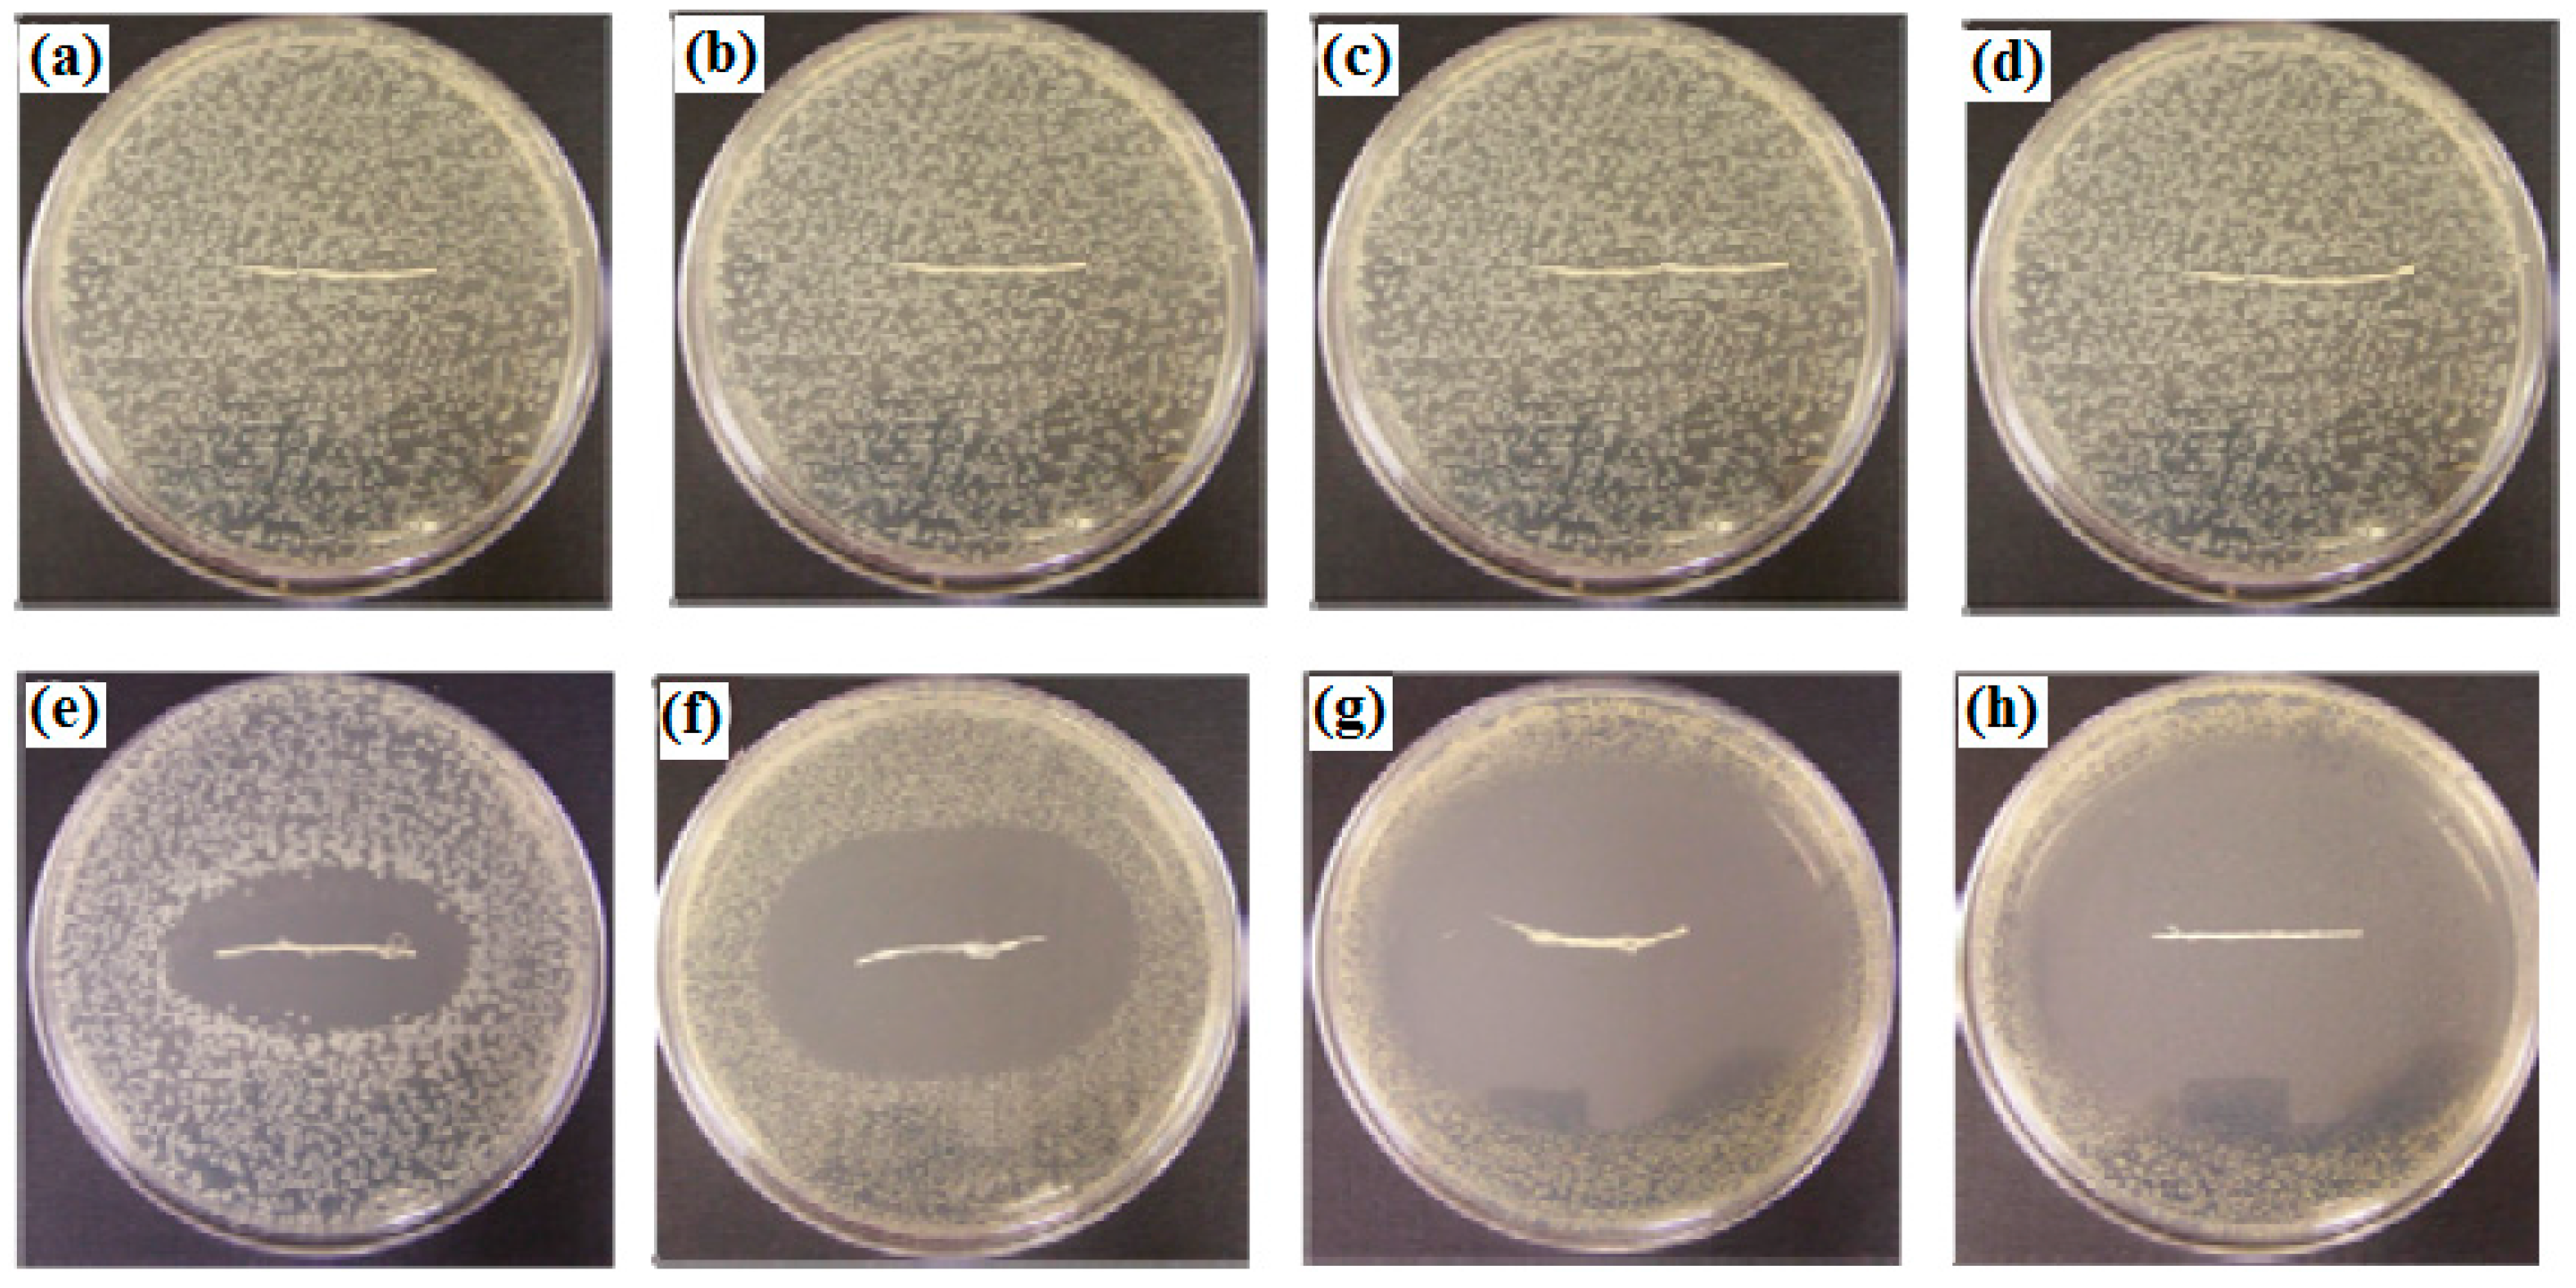

Synthesis of Antibacterial Silver–Poly(ɛ-caprolactone)-Methacrylic Acid Graft Copolymer Nanofibers and Their Evaluation as Potential Wound Dressing
Abstract
:1. Introduction
2. Experimental Methods
2.1. Materials
2.2. Grafting Copolymerization of MAA on to Polycaprolactone
2.3. Synthesis of PCL Nanofibers and PCL/MAA Nanofibers Containing AgNPs
2.4. Characterization of PCL/MAA Nanofibers Containing AgNPs
2.5. Atomic Absorption Analysis of AgNPs Leaching from PCL/MAA Electrospun Nanofibers
2.6. Water Uptake Measurement (WU)
2.7. Antimicrobial Activity of Electrospun PCL/MAA Copolymer Nanofibers Containing AgNPs
3. Results and Discussion
3.1. Characterization of Electrospun PCL/MAA Graft Copolymer Nanofibers


3.2. TEM Image of Electrospun PCL/MAA Copolymer Containing AgNPs

3.3. Water Uptake of Electrospun PCL/MAA Copolymer Nanofibers

3.4. Leaching of AgNPs from PCL/MAA Graft Copolymer Nanofibers

| Release Time (h) | Leaching Silver Concentration mg/100 g |
|---|---|
| 0 | 70 |
| 1 | 50 |
| 4 | 30 |
| 10 | 25 |
| 24 | 20 |
| 48 | 15 |
| 72 | 10 |
3.5. Antibacterial Activity of Electrospun PCL/MAA Containing AgNPs
| Sample | Clear Inhibition Zone Diameter (mm) | |||
|---|---|---|---|---|
| Gram negative bacteria | Gram positive bacteria | |||
| Escherichia coli | Pseudomonas aeruginosa | Staph. aurous | Bacillus thuringiensis | |
| PCL/MAA | 0 | 0 | 0 | 0 |
| PCL/MAA-AgNPs | 22 | 26 | 53 | 50 |
4. Conclusions
Acknowledgments
Conflicts of Interest
References
- New, N.; Furuike, T.; Tamura, H. The mechanical and biological properties of chitosan scaffolds for tissue regeneration templates are significantly enhanced by chitosan from Gongronella butleri. Materials 2009, 2, 374–398. [Google Scholar]
- Tran, D.L.; Pham, G.D.; Nguyen, X.P.; Vu, D.H.; Nguyen, N.T.; Tran, V.H.; Mai, T.T.T.; Nguyen, H.B.; Le, Q.D.; Nguyen, T.N.; et al. Some biomedical applications of chitosan-based hybrid nanomaterials. Adv. Nat. Sci. Nanosci. Nanotechnol. 2011, 2, 45004. [Google Scholar] [CrossRef]
- El-hefian, E.A. Characterization of chitosan in acetic acid: Rheological and thermal studies. Turk. J. Chem. 2010, 34, 47–56. [Google Scholar]
- Aranaz, I.; Mengíbar, M.; Harris, R. Functional characterization of chitin and chitosan. Curr. Chem. Biol. 2009, 3, 203–230. [Google Scholar]
- Lee, D.W.; Lim, H.; Chong, H.N.; Shim, W.S. Advances in chitosan material and its hybrid derivatives: A review. Open Biomater. J. 2009, 1, 10–20. [Google Scholar] [CrossRef]
- Jayakumar, R.; Prabaharan, M.; Nair, S.V.; Tamura, H. Novel chitin and chitosan nanofibers in biomedical applications. Biotechnol. Adv. 2010, 28, 142–150. [Google Scholar] [CrossRef] [PubMed]
- Bikiaris, D.N.; Papageorgiou, G.Z.; Achilias, D.S.; Pavlidou, E.; Stergiou, A. Miscibility and enzymatic degradation studies of poly(ε-caprolactone)/poly-(propylene succinate) blends. Eur. Polym. J. 2007, 43, 2491–2503. [Google Scholar] [CrossRef]
- Charuchinda, A.; Molly, R.; Siripitayananon, J.; Molloy, N.; Sriyai, M. Factors influencing the small-scale melt spinning of poly(ε-caprolactone) monofilament fibers. Polym. Int. 2003, 52, 1175–1181. [Google Scholar] [CrossRef]
- Cipitria, A.; Skelton, A.; Dargaville, T.R.; Dalton, P.D.; Hutmacher, D.W. Design, fabrication and characterization of PCL electrospun scaffolds—A review. J. Mater. Chem. 2011, 21, 9419–9453. [Google Scholar] [CrossRef]
- Khil, M.S.; Cha, D.I.; Kim, H.Y.; Kim, I.S.; Bhattarai, N. Electrospun nanofibrous polyurethane membrane as wound dressing. J. Biomed. Mater. Res. B 2003, 67, 675–679. [Google Scholar] [CrossRef] [PubMed]
- Alves, J.L.; Bellino, N.J.; Geraldes, M.J. Nano-bioabsorbent composite wound dressing for exudate management. WIREs Nanomed. Nanobiotechnol. 2010, 2, 510–525. [Google Scholar]
- Zahedi, P.; Rezaeian, I.; Ranaei-Siadat, S.; Jafari, S.; Supaphol, P. A review on wound dressings with an emphasis on electrospun nanofibrous polymeric bandages. Polym. Adv. Technol. 2010, 21, 77–95. [Google Scholar] [CrossRef]
- Kang, Y.O. Chitosan-coated poly(vinyl alcohol) nanofibers for wound dressings. J. Biomed. Mater. Res. B 2010, 92, 568–576. [Google Scholar] [CrossRef] [PubMed]
- Schneider, A.; Wang, X.Y.; Kaplan, D.L.; Garlick, J.A.; Egles, C. Biofunctionalized electrospun silk mats as a topical bioactive dressing for accelerated wound healing. Acta Biomater. 2009, 5, 2570–2578. [Google Scholar] [CrossRef] [PubMed]
- Merrell, J.G.; McLaughlin, S.W.; Tie, L.; Laurencin, C.T.; Chen, A.F.; Nair, L.S. Curcumin-loaded poly(ε-caprolactone) nanofibers: Diabetic wound dressing with anti-oxidant and anti-inflammatory properties. Clin. Exp. Pharmacol. Physiol. 2009, 36, 1149–1156. [Google Scholar] [CrossRef] [PubMed]
- Suwantong, O.; Ruktanonchai, U.; Supaphol, P. In vitro biological evaluation of electrospun cellulose acetate fiber mats containing asiaticoside or curcumin. J. Biomed. Mater. Res. A 2010, 94, 1216–1225. [Google Scholar] [PubMed]
- Hong, K.H. Preparation and properties of electrospun poly(vinyl alcohol)/silver fiber web as wound dressings. Polym. Eng. Sci. 2007, 47, 43–49. [Google Scholar] [CrossRef]
- Chen, J.; Chiang, Y. Bioactive electrospun silver nanoparticles-containing polyurethane nanofibers as wound dressings. J. Nanosci. Nanotechnol. 2010, 10, 7560–7564. [Google Scholar] [CrossRef] [PubMed]
- Ignatova, M.; Manolova, N.; Rashkov, I. Electrospinning of poly(vinyl pyrrolidone)–iodine complex and poly(ethylene oxide)/poly(vinyl pyrrolidone)-iodine complex—A prospective route to antimicrobial wound dressing materials. Eur. Polym. J. 2007, 43, 1609–1623. [Google Scholar] [CrossRef]
- Kenawy, E.-R.; Bowlin, G.L.; Mansfield, K.; Layman, J.; Simpson, D.G.; Sanders, E.H.; Wnek, G.E. Release of tetracycline hydrochloride from electrospun poly(ethylene-co-vinylacetate), poly(lactic acid), and a blend. J. Control. Release 2002, 81, 57–64. [Google Scholar] [CrossRef]
- Sosa, I.O.; Noguez, C.; Barrera, R.G. Optical properties of metal nanoparticles with arbitrary shapes. J. Phys. Chem. B 2003, 107, 6269–6275. [Google Scholar] [CrossRef]
- Murthy, P.S.K.; Moha, Y.M.; Varaprasa, K.D.; Sreedhar, B.; Raju, K.M. First successful design of semi-IPN hydrogel-silver nanocomposites: A facile approach for antibacterial application. J. Colloid Interface Sci. 2008, 318, 217–224. [Google Scholar] [CrossRef] [PubMed]
© 2015 by the authors; licensee MDPI, Basel, Switzerland. This article is an open access article distributed under the terms and conditions of the Creative Commons Attribution license (http://creativecommons.org/licenses/by/4.0/).
Share and Cite
Al-Omair, M.A. Synthesis of Antibacterial Silver–Poly(ɛ-caprolactone)-Methacrylic Acid Graft Copolymer Nanofibers and Their Evaluation as Potential Wound Dressing. Polymers 2015, 7, 1464-1475. https://doi.org/10.3390/polym7081464
Al-Omair MA. Synthesis of Antibacterial Silver–Poly(ɛ-caprolactone)-Methacrylic Acid Graft Copolymer Nanofibers and Their Evaluation as Potential Wound Dressing. Polymers. 2015; 7(8):1464-1475. https://doi.org/10.3390/polym7081464
Chicago/Turabian StyleAl-Omair, Mohammed A. 2015. "Synthesis of Antibacterial Silver–Poly(ɛ-caprolactone)-Methacrylic Acid Graft Copolymer Nanofibers and Their Evaluation as Potential Wound Dressing" Polymers 7, no. 8: 1464-1475. https://doi.org/10.3390/polym7081464
APA StyleAl-Omair, M. A. (2015). Synthesis of Antibacterial Silver–Poly(ɛ-caprolactone)-Methacrylic Acid Graft Copolymer Nanofibers and Their Evaluation as Potential Wound Dressing. Polymers, 7(8), 1464-1475. https://doi.org/10.3390/polym7081464
